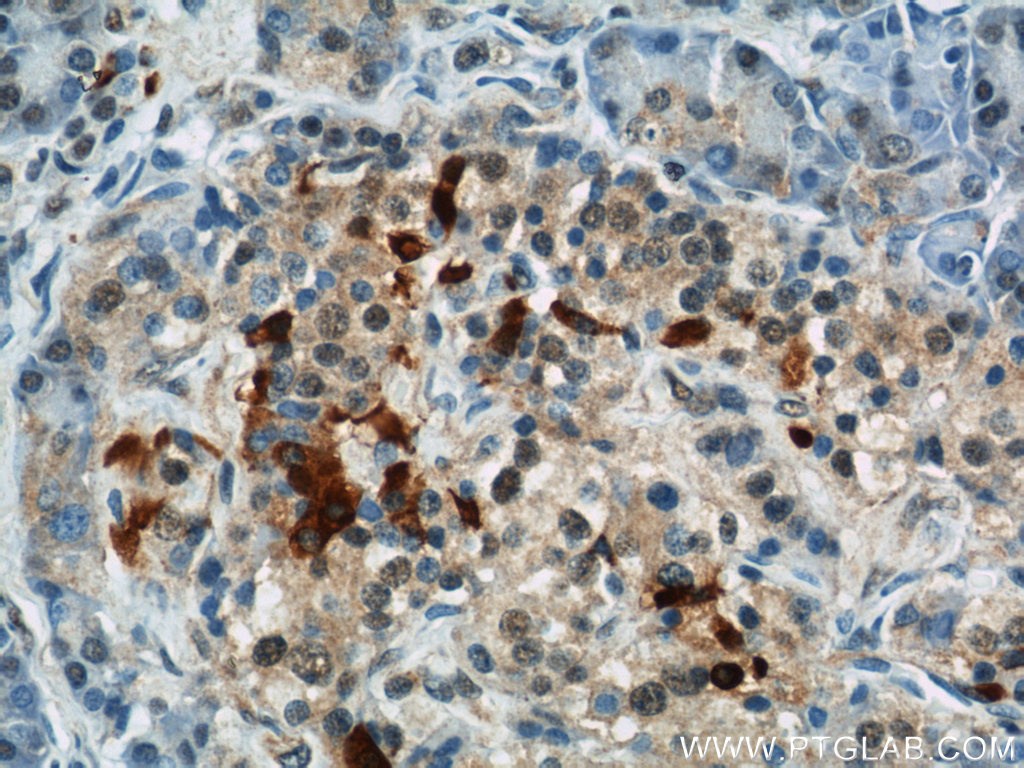

验证数据展示
经过测试的应用
| Positive WB detected in | HEK-293 cells, mouse retina tissue, NIH/3T3 cells |
| Positive IP detected in | HEK-293 cells |
| Positive IHC detected in | human prostate cancer tissue, human pancreas tissue Note: suggested antigen retrieval with TE buffer pH 9.0; (*) Alternatively, antigen retrieval may be performed with citrate buffer pH 6.0 |
| Positive IF/ICC detected in | hTERT-RPE1 cells |
推荐稀释比
| 应用 | 推荐稀释比 |
|---|---|
| Western Blot (WB) | WB : 1:500-1:2000 |
| Immunoprecipitation (IP) | IP : 0.5-4.0 ug for 1.0-3.0 mg of total protein lysate |
| Immunohistochemistry (IHC) | IHC : 1:50-1:500 |
| Immunofluorescence (IF)/ICC | IF/ICC : 1:200-1:800 |
| It is recommended that this reagent should be titrated in each testing system to obtain optimal results. | |
| Sample-dependent, Check data in validation data gallery. | |
产品信息
11083-1-AP targets IFT57 in WB, IHC, IF/ICC, IP, ELISA applications and shows reactivity with human, mouse, rat, canine samples.
| 经测试应用 | WB, IHC, IF/ICC, IP, ELISA Application Description |
| 文献引用应用 | WB, IF, IP |
| 经测试反应性 | human, mouse, rat, canine |
| 文献引用反应性 | human, mouse, rat, chicken |
| 免疫原 |
CatNo: Ag1566 Product name: Recombinant human IFT57 protein Source: e coli.-derived, PGEX-4T Tag: GST Domain: 1-429 aa of BC011899 Sequence: MTAALAVVTTSGLEDGVPRSRGEGTGEVVLERGPGAAYHMFVVMEDLVEKLKLLRYEEEFLRKSNLKAPSRHYFALPTNPGEQFYMFCTLAAWLINKAGRPFEQPQEYDDPNATISNILSELRSFGRTADFPPSKLKSGYGEHVCYVLDCFAEEALKYIGFTWKRPIYPVEELEEESVAEDDAELTLNKVDEEFVEEETDNEENFIDLNVLKAQTYHLDMNETAKQEDILESTTDAAEWSLEVERVLPQLKVTIRTDNKDWRIHVDQMHQHRSGIESALKETKGFLDKLHNEITRTLEKISSREKYINNQLENLVQEYRAAQAQLSEAKERYQQGNGGVTERTRLLSEVMEELEKVKQEMEEKGSSMTDGAPLVKIKQSLTKLKQETVEMDIRIGIVEHTLLQSKLKEKSNMTRNMHATVIPEPATGFY 种属同源性预测 |
| 宿主/亚型 | Rabbit / IgG |
| 抗体类别 | Polyclonal |
| 产品类型 | Antibody |
| 全称 | intraflagellar transport 57 homolog (Chlamydomonas) |
| 别名 | Dermal papilla-derived protein 8, DERP8, ESRRBL1, Estrogen-related receptor beta-like protein 1, HIP1-interacting protein |
| 计算分子量 | 49 kDa |
| 观测分子量 | 49 kDa |
| GenBank蛋白编号 | BC011899 |
| 基因名称 | IFT57 |
| Gene ID (NCBI) | 55081 |
| RRID | AB_2121957 |
| 偶联类型 | Unconjugated |
| 形式 | Liquid |
| 纯化方式 | Antigen affinity purification |
| UNIPROT ID | Q9NWB7 |
| 储存缓冲液 | PBS with 0.02% sodium azide and 50% glycerol, pH 7.3. |
| 储存条件 | Store at -20°C. Stable for one year after shipment. Aliquoting is unnecessary for -20oC storage. |
背景介绍
IFT57, also named as DERP8, ESRRBL1, HIPPI and MHS4R2, belongs to the IFT57 family. It is required for the formation of cilia. IFT57 plays an indirect role in sonic hedgehog signaling, cilia being required for all activity of the hedgehog pathway. It is a component of IFT complex B which composed of IFT88, IFT57, TRAF3IP1, IFT52, IFT27, HSPB11 and IFT20. In contrast to BBS proteins, IFT57 and IFT88 is found in almost every cilium.(PMID:22072986)
实验方案
| Product Specific Protocols | |
|---|---|
| IF protocol for IFT57 antibody 11083-1-AP | Download protocol |
| IHC protocol for IFT57 antibody 11083-1-AP | Download protocol |
| IP protocol for IFT57 antibody 11083-1-AP | Download protocol |
| WB protocol for IFT57 antibody 11083-1-AP | Download protocol |
| Standard Protocols | |
|---|---|
| Click here to view our Standard Protocols |
发表文章
| Species | Application | Title |
|---|---|---|
Nat Cell Biol The Cep63 paralogue Deup1 enables massive de novo centriole biogenesis for vertebrate multiciliogenesis. | ||
Nat Cell Biol Systematic proteomics of the VCP-UBXD adaptor network identifies a role for UBXN10 in regulating ciliogenesis. | ||
Dev Cell The Intraflagellar Transport Protein IFT27 Promotes BBSome Exit from Cilia through the GTPase ARL6/BBS3. | ||
Nat Commun IFT proteins spatially control the geometry of cleavage furrow ingression and lumen positioning. | ||
EMBO J Rabl2 GTP hydrolysis licenses BBSome-mediated export to fine-tune ciliary signaling. | ||
Proc Natl Acad Sci U S A Primary cilia signaling mediates intraocular pressure sensation. |